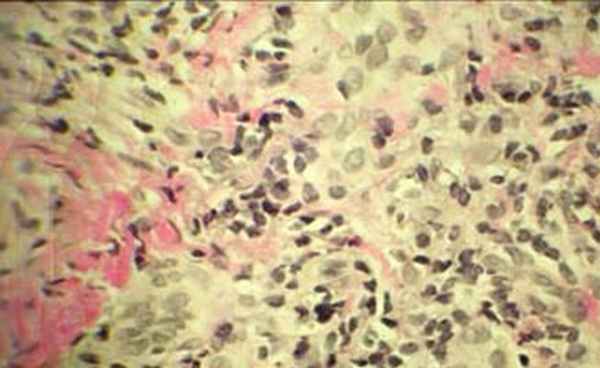
Рецидивирующий полихондрит

Рецидивирующий полихондрит
Добавил пользователь Дмитрий К. Обновлено: 22.11.2025
Пациент М., 36 лет, поступил в НМХЦ им. Н.И. Пирогова в августе 2007 с жалобами на болезненную припухлость, покраснение и деформацию ушных раковин (больше выраженную слева), боль, скованность в суставах кистей, дискомфорт в области гортани при глотании, повышение температуры тела до 37,5-38 °С, общую слабость, утомляемость. Заболел остро в мае 2007 года, когда появилась болезненная припухлость, гиперемия левой ушной раковины (травму, инсоляцию отрицает), через несколько недель присоединились боль в мелких суставах кистей, подъем температуры до субфебрильных цифр. Осмотрен ЛОР-врачом, инфекционистом, дерматологом аллергологом, хирургом по месту жительства, которые предполагали вирусные, паразитарные заболевания, гнойное воспаление ушной раковины, аллергическую реакцию. Для уточнения диагноза пациент госпитализирован по месту жительства, где клинический анализ крови в пределах нормы, СРБ 32 мг/л (норма до 6 мг/л), рентгенография кистей – без эрозивных изменений, рентгенография органов грудной клетки – в пределах нормы, УЗИ органов брюшной полости, щитовидной железы, почек – без патологии. В течение 3-х месяцев проводилась терапия антибиотиками различных групп (цефалоспорины, фторхинолоны, макролиды, тетрациклины) в сочетании с нестероидными противовоспалительными препаратами, антигистаминными препаратами без существенного эффекта. Однократно в область ушной раковины введен преднизолон (доза не указана). В связи с отсутствием эффекта от проводимой терапии и прогрессирующим течением заболевания переведен в НМХЦ.
При поступлении гиперемия, выраженная припухлость, деформация и резкая болезненность левой ушной раковины (рис 1), умеренная припухлость без деформации правой ушной раковины (рис 2). Припухлость пястно-фаланговых суставов II-IV пальцев кистей (рис 3), симптом сжатия кистей положительный, сила в кистях умеренно снижена. Дыхание через нос свободное, в легких везикулярное дыхание, хрипов нет. ЧД 16 в минуту. Пульс 72 в минуту, ритм правильный, тоны сердца ясные, шумы не выслушиваются. АД 130/80 мм рт.ст. Температура тела 38 °С, общая слабость, утомляемость, снижен фон настроения. В клиническом анализе крови ускорение СОЭ до 68 мм/ч, лейкоцитоз до 10х109/л, ревматоидный фактор крови – отрицательный. Рентгенография мягких тканей шеи не выявила сужение воздушного столба в трахее.
![]() | ![]() |
| Рис 1. Левая ушная раковина до и через 2 недели терапии кортикостероидами | |
![]() | ![]() |
| Рис 2. Правая ушная раковина до и через 2 недели терапии кортикостероидами | |
![]() |
| Рис 3. |
Клиническое течение заболевания позволило заподозрить рецидивирующий полихондрит. Диагноз подтвержден результатами выполненной биопсии левой ушной раковины: перихондральное воспаление, гранулоцитарная инфильтрация (рис. 3а, 3б).
![]() | ![]() |
| Рис 3а. Гистологическое исследование биопсии ушной раковины Ув. 1:40 | Рис 3б. Гистологическое исследование биопсии ушной раковины Ув. 1:400 |
Начата терапия: солумедрол в/в капельно (суммарно 1 гр), метилпреднизолон внутрь 32 мг/сутки. В ближайшие дни стойкая нормализация температуры тела, уменьшение припухлости, боли в левой ушной раковине (рис 1), регресс припухлости и болей в правой ушной раковине (рис. 2) и суставах, нормализовалось настроение, в последующем снижение СОЭ до 16 мм/ч. Таким образом, через три месяца со времени появления первых клинических проявлений заболевания диагностирован рецидивирующий полихондрит. Ранняя постановка диагноза и адекватная терапия позволили быстро оборвать воспалительный процесс и избежать развития необратимых изменений хрящевой ткани, требующих порой проведения тяжелых реконструктивных, пластических операций на гортани, трахеи, аорте, клапанах сердца. Рецидивирующий полихондрит относится к ургентным заболеваниям. С момента постановки диагноза до смерти проходит от 10 мес. до 20 лет. Наиболее грозными проявлениями заболевания помимо поражения респираторного тракта (56%), является вовлечение в воспалительный процесс сердечно-сосудистой системы (24%), с развитием аортита, аневризмы аорты, артериальных тромбозов, недостаточности аортального, митрального клапанов, блокад проведения и инфаркта миокарда, васкулита [2].
Плохими прогностическими признаками являются: дебют в молодом возрасте, системный васкулит, ранняя седловидная деформация носа, анемия у пожилых [2]. Крупное исследование, проведенное в клинике Мейо, показало, что в группе из 112 пациентов 5-летняя выживаемость составила 74%, 10-летняя – 55%. Основными причинами смерти были инфекционные заболевания и системный васкулит, 15% больных умерли от поражения дыхательных путей и сердца. Редкость заболевания и малая осведомленность врачей различных специальностей побуждают пациентов и специалистов, занимающихся проблемой рецидивирующего полихондрита объединяться. В интернете созданы сайты поддержки пациентов, их друзей и родственников. Единичные случаи врачебного наблюдения непременно публикуются в медицинских изданиях, на сайтах в интернете.
Список литературы:
- McAdam L.P., O"Hanlan M.A., Bluestone R., Pearson C.M. Relapsing polychondritis:prospective study of 23 patients and revive of the literature, Medicine (Baltimore) 1976; 55:193-215
- Michet CJ. Jr., McKenna C.H., Luthra H.S., OFallon W.M. Relapsing polychondritis: survival and predictive role of early disease manifestations. Ann Intern Med. 1986, 104:74-78.
- Pearson C.M, Kline H.M., Newcomer V.D. Relapsing polychondritis. N Engl J Med 1960; 263:51-58.
- Foldart J.M., Abe S., Martin G.I.R., Zizic T.M. et al. Antibodies to type II collagen in relapsing polychondritis. N. EngI. J. Med. 1978; 299:1203-1207.
© 2022 ФГБУ «НМХЦ им. Н.И. Пирогова» Минздрава России. Использование материалов сайта полностью или частично без письменного разрешения строго запрещено.
Рецидивирующий полихондрит
Рецидивирующий полихондрит (РПХ) — это редкое системное заболевание с волнообразным течением, предположительно аутоиммунной природы, характеризующееся периодически возникающими обострениями воспалительного процесса в хрящевых тканях, приводящими к их разрушению[5]. Поражаются в равной степени мужчины и женщины. Заболевают лица в возрасте от 20 до 60 лет, пик приходится на 40 лет. Рецидивирующий полихондрит впервые был описан в Jaksch-Wartenhorst в 1927г. Заболевание это достаточно редкое и в клинической практике встречается с частотой 3,5 случая на 1000000 населения.В процесс вовлекаются органы, содержащие большое количество протеингликанов: уши, нос, трахея, суставы, глаза, аорта, сердце, кожа. Исследования показывают, что при этом заболевании часто выявляется HLA-DR4, прослеживается Т-клеточная иммунная реакция на коллаген 2 типа с продукцией фактора некроза опухоли (ФНО), который стимулирует синтез и высвобождение протеиназ, разрушающих хрящ, в последующем замещающийся соединительной тканью с развитием фиброза. Анализ 159 случаев РПХ показал [2], что заболевание имеет рецидивирующей течение. Чаще всего первыми поражаются ушные раковины и/или развивается полиартрит. В последующем у каждого второго больного вовлекаются хрящи воздухоносных путей, что проявляется болями в горле, диспноэ, дисфагией, стридорозным дыханием. В 10-20% случаев причиной смерти является поражение легких и реже – поражения клапанов сердца. Описаны единичные случаи вовлечения в патологический процесс периферической нервной системы [4]. В 30% случаев другие нозологические формы аутоиммунных заболеваний предшествуют развитию рецидивирующего полихондрита. Диагноз заболевания выставляется с учетом клинико-лабораторных данных по диагностическим критериям, разработанным Мак-Адамом в 1976г. [5].
Об авторах
Список литературы
1.
Агабабова Э.Р. Рецидивирующий полихондрит и синдром Титце. В кн. Клиническая ревматология В. А. Насонова, М. Г. Астапенко. М. Медицина, 1989, 222-45
Алекберова З.С., Сигидин Я.А. Рецидивирующий полихондрит. Тер. архив, 1984, 8, 125-7
Алекберова З.С. Рецидивирующий полихондрит в кн. Ревматические болезни под ред. В.А. Насоновой, Н.В. Бунчука. Москва: Медицина, 1997, 216-8
Marie I, Martinaud O, Omnient Y, Mihout B, Levesque H. Facial diplegia revealing relapsing polychondritis. Rheumatology, 2005, 44(6), 827 – 8.
McAdam L. P., O’Hanlan M. A., Bluestone R., Pearson C. M. Relapsing polychondritis: prospective study of 23 patients and a review of the literature. Medicine (Baltimore), 1976, 55(3), 193 – 215.
Mpofu S, Estrach C, Curtis J, Moots R. J. Treatment of respiratory complications in recalcitrant relapsing polychondritis with infliximab. Rheumatology, 2003, 42, 1117 –8.
Vounotrypidis P, Sakellariou G. T., Zisopoulos D., Berberidis C. Refractory relapsing polychondritis: rapid and sustained response in the treatment with an IL-1 receptor antagonist (anakinra). Rheumatology, 2006, 45(4), 491 – 2.
Рецензия
Для цитирования:
For citation:
Контент доступен под лицензией Creative Commons Attribution 4.0 License.
Рецидивирующий полихондрит
Пермская государственная медицинская академия им. акад. Е.А. Вагнера
Пермская государственная медицинская академия им. акад. Е.А. Вагнера
Пермская государственная медицинская академия им. акад. Е.А. Вагнера
Пермская государственная медицинская академия им. акад. Е.А. Вагнера
Пермская государственная медицинская академия им. акад. Е.А. Вагнера
Полихондрит рецидивирующий атрофический: два клинических наблюдения
Журнал: Клиническая дерматология и венерология. 2011;9(3): 23‑26
Елькин В.Д., Митрюковский Л.С., Счастливцева Л.В., Плотникова Е.В., Бязрова Ф.Ф. Полихондрит рецидивирующий атрофический: два клинических наблюдения. Клиническая дерматология и венерология. 2011;9(3):23‑26.
El'kin VD, Mitriukovskiĭ LS, Schastlivtseva LV, Plotnikova EV, Biazrova FF. Recurrent atrophic polychondritis: two clinical observations. Klinicheskaya Dermatologiya i Venerologiya. 2011;9(3):23‑26. (In Russ.).
Пермская государственная медицинская академия им. акад. Е.А. Вагнера
Представлены два клинических случая полихондрита рецидивирующего атрофического. Описаны этиология, патогенез, клинические и патоморфологические критерии диагностики, рассмотрены проблемы дифференциальной диагностики и тактики ведения пациентов с данным заболеванием.
Пермская государственная медицинская академия им. акад. Е.А. Вагнера
Пермская государственная медицинская академия им. акад. Е.А. Вагнера
Пермская государственная медицинская академия им. акад. Е.А. Вагнера
Пермская государственная медицинская академия им. акад. Е.А. Вагнера
Пермская государственная медицинская академия им. акад. Е.А. Вагнера
Полихондрит рецидивирующий атрофический (системная хондромаляция, полихондропатия, синдром Мейенбурга—Альтерра—Юлингера) — системное поражение соединительной ткани с полиорганной патологией. Первые публикации о данном заболевании относятся к 1923 г. (R. Jaksch—Wartenhorst) и 1936 г. (F. Altherr). Современное название в 1960 г. предложили С. Pearson, H. Kline и V. Newcomer.
Этиология и патогенез данного заболевания полностью не изучены. Предполагается аутоиммунный механизм развития, обусловленный образованием аутоантител, мишенью которых являются коллаген, эластин, протеогликаны. В период острого воспаления в сыворотке выявляются высокие титры антител к коллагену II, IX и XI типа. Повышены также титры циркулирующих иммунных комплексов, коррелирующие с активностью процесса [1–5]. Описаны случаи комбинации полихондрита с болезнью Бехчета (синдром MAGIC), системной красной волчанкой. Иногда заболевание расценивают как паранеопластический процесс, развивающийся на фоне миелодисплазии и других злокачественных заболеваний крови [2, 6, 7].
Болеют мужчины и женщины в любом возрасте. Изменения кожи наблюдаются в 20—50% случаев. Почти постоянным признаком (в 90% случаев) является поражение ушных раковин, проявляющееся рецидивирующими эпизодами болезненности, отека и гиперемии продолжительностью от нескольких дней до нескольких недель. Поражение двустороннее, сопровождается снижением слуха за счет сужения слуховых проходов. В результате повторных атак и постепенного разрушения хряща ушные раковины сморщиваются, приобретают вид «мокрой тряпки», «цветной капусты». Кроме указанных поражений кожи ушных раковин и периорбитального отека, встречаются случаи с развитием лейкоцитокластического васкулита, стерильных пустулезов, сетчатого ливедо, пурпурозных высыпаний, септального панникулита.
Вовлечение хрящей носа, сопровождающееся ринореей, заканчивается изменением конфигурации спинки и крыльев носа (седловидный нос и другие варианты) у 50—70% больных [2, 3, 8, 9].
Весьма опасным является поражение хрящей гортани, трахеи, бронхов, завершающееся их размягчением, обструкцией дыхательных путей, развитием вторичной инфекции, что может привести к летальному исходу.
Поражаются суставы (асимметричные мигрирующие артриты). Наблюдается тенденция к вовлечению грудиноключичных сочленений, костно-хрящевого отдела ребер.
Возникают поражения глаз (периорбитальные отеки, конъюнктивит, эписклерит, кератит, увеит, иридоциклит, хориоретинит, кератомаляция, отслойка сетчатки). Глазная патология может служить маркером тяжести течения заболевания [3, 10, 11].
С поражением эластических волокон крупных сосудов связано развитие сердечно-сосудистой патологии (аневризма аорты, повышенная вероятность тромбозов).
Редко наблюдаются поражения центральной нервной системы (дисфункция черепно-мозговых нервов, мозжечковые симптомы, гемиплегия, эпилепсия, деменция) [2, 6, 7].
Лабораторные показатели неспецифичны. С разной частотой наблюдаются повышение скорости оседания эритроцитов (СОЭ), анемия, лейкоцитоз, эозинофилия, повышение титра антистрептолизиновых антител. Иногда выявляются ревматоидный фактор, LE-клетки, антиядерные антитела, криоглобулинемия. Возможны положительные серореакции на сифилис.
Рентгенологически в хрящах носа, гортани, трахеи могут быть выявлены кальцификаты.
Наблюдаются следующие гистопатологические изменения: потеря хрящевым матриксом гликозаминов, инфильтрация хряща лимфоцитами и плазматическими клетками, нейтрофилами. Образуется грануляционная ткань, в заключительной стадии — фиброз.
Заболевание отличается хроническим рецидивирующим течением, чаще затяжным, реже молниеносным. Особенно плохой прогноз с летальным исходом — при кардиопульмональной патологии.
Лечение заболевания малоэффективно. Кортикостероиды, цитостатики (азатиоприн, циклофосфан), пульс-терапия кортикостероидами в сочетании с циклофосфаном, дапсон, циклоспорин дают временное улучшение. При поражении аорты используют протезирование аортальных клапанов [2—4, 12].
Сходная симптоматика имеет место при ряде заболеваний. Дифференциальную диагностику нужно проводить с поздними формами сифилиса, системной красной волчанкой, синдромом Марфана.
При третичном и позднем врожденном сифилисе, кроме характерной клинической картины, в верификации диагноза помогают положительные результаты трепонемных серологических тестов (реакция флюоресценции, реакция иммобилизации бледных трепонем, реакция пассивной гемагглютинации, иммуноферментный анализ).
Красная волчанка — аутоиммунное заболевание с преимущественным поражением соединительной ткани, завершающееся ее деструкцией. В патогенезе основную роль играют разные аутоантитела, в том числе и органоспецифичные, а также иммунные комплексы, обусловливающие мультиорганное поражение.
Характерно поражение мягких тканей выступающих частей лица и конечностей. Хрящевые субстанции не страдают. Имеет место выраженная фоточувствительность.
Лабораторные показатели: анемия, снижение гемоглобина, лейкопения, повышение СОЭ, наличие LE-клеток, ревматоидного фактора, антиядерных антител.
При синдроме Марфана имеются характерный внешний вид больных (акромегалия, высокий рост, воронкообразная грудная клетка, удлиненные тонкие конечности), экзостозы, патологическая растяжимость суставов, недоразвитие мышц, стрии, гипотрофия подкожной клетчатки, анетодермия, геродермия, аномалии расположения зубов, гиподонтия, а также гидроцефалия, патология центральной нервной системы и мультиорганная патология.
В качестве иллюстрации приводим два клинических случая рецидивирующего атрофического полихондрита с разными исходами болезни.
Пациент Ж., 1951 г. рождения, житель Соликамска, поступил в стационар ККВД №1 Пермского края в ноябре 2007 г. с диагнозом дерматит ушных раковин.
В течение года пациента беспокоили периодическая болезненность, отек и гиперемия обеих ушных раковин. Симптомы появлялись без видимой причины и сохранялись от нескольких дней до 3–4 нед. Около 6 мес назад появились деформация ушных раковин, сужение слухового прохода. В течение последних 5 мес отмечено снижение слуха. Обращался к дерматологу по месту жительства. Был поставлен диагноз дерматит ушных раковин. Проводилась десенсибилизирующая терапия, наружно использовались топические стероиды. Эффекта от лечения не наблюдалось. В июле 2007 г. консультирован дерматологом и аллергологом в ККБ Пермского края. Заключение: данных за аллергическое заболевание ушных раковин нет. Для уточнения диагноза и определения дальнейшей тактики госпитализирован в стационар ККВД №1.
При поступлении общее состояние пациента было удовлетворительным.

Специальный статус: патологический процесс симметричный, локализуется на обеих ушных раковинах, кожа которых умеренно гиперемирована. Ушные раковины сморщены, деформированы, имеют вид «мокрой тряпки» (рис. 1). Рисунок 1. Пациент Ж. Деформация правой (а) и левой (б) ушной раковины по типу «мокрая тряпка».
Общеклинические анализы: вариант нормы.
Биохимические показатели: глюкоза — 6,14 ммоль/л, остальные — в норме.
Рентгенография грудной клетки: хондрит респираторного тракта. Стриктуры бронхов и трахеи.
Консультация терапевта: сахарный диабет 2-го типа. Ожирение I степени. Узловой зоб. Гипертоническая болезнь II степени, риск 3. Дисциркуляторная энцефалопатия I степени.
Консультация ревматолога: диагноз полихондрит подтвержден.

Патогистологическое исследование. Биопсия правой ушной раковины: отмечается хаотичное расположение и фрагментация коллагеновых волокон, разрыхление стромы (рис. 2, а). Рисунок 2. Биопсия правой ушной раковины. а — отмечаются хаотичное расположение и фрагментация коллагеновых волокон, разрыхление стромы; б — хрящевая ткань окрашена эозинофильно, построена в виде островков, между которыми встречаются скопления лимфоцитов; в — хондроциты с выраженными дистрофическими изменениями, ядра в них разных размеров, встречаются пустые хрящевые капсулы. Хрящевая ткань окрашена эозинофильно, построена в виде островков, между которыми встречаются скопления лимфоцитов (рис. 2, б). Хондроциты с выраженными дистрофическими изменениями, ядра в них разных размеров; встречаются пустые хрящевые капсулы (рис. 2, в). Заключение: дисплазия соединительной ткани и хряща ушной раковины.
Получал симптоматическое лечение. Для дальнейшего обследования и лечения направлен к ревматологу.
Пациент Ч., 35 лет. После операции по поводу искривления носовой перегородки произошла резкая деформация носа. Через 2 года воспалилась и деформировалась левая ушная раковина. В дальнейшем деформировалась и правая ушная раковина. Госпитализировался в ЛОР- и глазное отделения по поводу неврита слуховых нервов, склеро-керато-ирита. В связи с подозрением на сифилис неоднократно обследовался в дерматовенерологических учреждениях.
В 1981 г. поступил в клинику кожных болезней.

При осмотре обращала на себя внимание деформация ушных раковин и носа. Уши уменьшены за счет сморщивания хрящей, нос седловидный, с резко запавшей спинкой (рис. 3). Рисунок 3. Пациент Ч. Деформация ушных раковин, седловидный нос.
При отоларингологическом обследовании определялись рубцовые изменения в гортани, диагностирована нейросенсорная глухота на оба уха.
При рентгенологическом обследовании выявлены аневризмы аорты в грудном и брюшном отделах. Данных за сифилис нет (клиническая картина отсутствует, серореакции отрицательные).
Через 1,5 мес больной скоропостижно скончался от разрыва грудной аневризмы аорты.
Представленные случаи интересны тем, что практические врачи малознакомы с этой патологией, и, как правило, постановка диагноза представляет значительные сложности. Если в первом случае правильный диагноз был поставлен в течение 1 года, то для диагностики второго понадобилось 16 лет с учетом того, что клиническая картина заболевания, и в первую очередь поражение ушных раковин, у обоих больных было характерным, по сути, специфичным для данного заболевания. Кроме того, также не исключено, что своевременная диагностика и более раннее начало лечения позволят замедлить наступление грозных симптомов заболевания.
Резистентный рецидивирующий полихондрит

Рецидивирующий полихондрит представляет собой тяжелое системное иммуноопосредованное заболевание, характеризующееся эпизодическим, прогрессирующим воспалением с постепенным разрушением хрящевых структур ушей, носа, ларинготрахеобронхиального дерева и суставов. Также могут быть затронуты богатые протеогликанами органы, такие как глаза, сердце, кровеносные сосуды, внутреннее ухо и кожа. Рецидивирующий полихондрит может проявляться как самостоятельное заболевание или сопровождаться другими нарушениями.
Болезнь по-прежнему привлекает интерес научного сообщества из-за низкой частоты, невыясненного этиопатогенеза, клинического полиморфизма, непрогнозируемого течения и отсутствия определенного лечебного подхода. Таким образом, несмотря на научный прогресс и современные представления о рецидивирующем полихондрите, проблема прошлого века все еще не раскрыта на надлежащем уровне. Один из недавних научных обзоров, опубликованный в сентябре 2017 г. в журнале «Open Access Rheumatology», призван восполнить недостаток и систематизировать знания касательно этого редкого заболевания. Работа выполнена совместно учеными Университета Буэа (University of Buea), Камерун, и Университета Париж XII (University Paris 12), Франция.
Предыстория вопроса
Подробно заболевание описано в 1923 г. доктором Р. Якш-Вартенхорстом (R. Jaksh-Wartenhorst), который дал ему первоначальное название «полихондропатия». Нынешний термин — рецидивирующий полихондрит был предложен К. Пирсоном и соавторами (Pearson C. еt al.) в 1960 г. на основе описания четырех текущих и обзоре двенадцати предыдущих случаев этого заболевания. Авторы четко определили рецидивирующий полихондрит как интенсивное воспалительное состояние хрящевых и нехрящевых тканей. Также отмечено, что после некоторых эпизодов воспаления происходит замена хряща волокнистой соединительной тканью.
Клинические проявления
Течение рецидивирующего полихондрита характеризуется клиническим полиморфизмом в такой степени, что трактование симптомов требует междисциплинарного врачебного участия не менее пяти специалистов. Множественные клинические проявления и эпизодический характер заболевания значительно задерживают определение диагноза (от 1,9 года до 10 лет в среднем). Начальные проявления рецидивирующего полихондрита, как правило, ярко выраженные и острые. Типичные признаки: хондрит ушей с болью, эритемой и отеком, в сочетании с хондритом носа. Впоследствии могут возникать хондриты реберно-хрящевых суставов и верхних дыхательных путей, склерит и эписклерит, артралгия и различные поражения слизистой оболочки. Повторное воспаление может привести к разрушению хряща и деформации носа, ушей и дыхательных путей. Наиболее грозными осложнениями являются трахеобронхомаляция и вовлечение в патологический процесс восходящей части аорты. Лихорадка, астения, потеря массы тела или сыпь могут быть при этом начальными симптомами.
Ревматологический процесс при рецидивирующем полихондрите варьирует от простой артралгии до асимметричного, мигрирующего и неэрозивного артрита, но особо предрасположены к поражению реберно-хрящевые суставы. Ревматологические проявления, как правило, развиваются постепенно, в течение длительного времени, а их частота варьирует в зависимости от продолжительности, активности и тяжести основного заболевания. Кроме клинической гетерогенности, к ошибкам в диагностике приводят первоначальные проявления рецидивирующего полихондрита (которые чаще всего являются внехрящевыми), а также незнание клиники этого редкого заболевания. В случаях, когда ревматологические симптомы предшествуют ушному и носовому хондриту (и/или когда эпизоды хондрита игнорируются), определение истинного диагноза усложняется, однако не становится невозможным, поскольку несколько клиницистов в процессе лечения должны исключать рецидивирующий полихондрит у пациентов с артритом.
У ⅓ пациентов с рецидивирующим полихондритом выявляют интеркуррентные процессы, включая системный васкулит, воспалительные и гематологические заболевания. Признаки сопутствующей патологии могут предшествовать, проявляться после или присутствовать одновременно с рецидивирующим полихондритом. Дифференциальная диагностика на ранней стадии довольно проблематична, особенно при системном ANCA-положительном васкулите. Лучшее знание патологии ANCA-положительного васкулита позволяет проводить дифференцировку между рецидивирующим полихондритом и гранулематозом с полиангиитом, даже если во время системного васкулита присутствуют классические признаки вовлечения в патологический процесс хрящевой ткани носа.
Не менее сложно отличить рецидивирующий полихондрит от болезни Бехчета, при которой клиническая картина одного заболевания накладывается на другое (синдром MAGIC). Хондрит также типичен для системной красной волчанки. Случаи аурикулярного хондрита, имитирующие рецидивирующий полихондрит, описаны у пациентов с лепрой и сопутствующим артритом. Миелодиспластический синдром выявляют у 8–40% пациентов с рецидивирующим полихондритом, главным образом среди мужчин в возрасте старше 60 лет.
Отличия между почечными поражениями при рецидивирующем полихондрите и сопутствующими заболеваниями, такими как системный васкулит или системная красная волчанка, вызывают много вопросов. Нарушения функции почек, выявляемые у 22% пациентов с рецидивирующим полихондритом, характеризуются повышением креатинина сыворотки крови, протеинурией и гематурией. Биопсия почек при этом может выявить умеренное мезангиальное расширение и клеточную пролиферацию, сегментарный серповидный некротизирующий гломерулонефрит, сегментарную мезангиальную пролиферацию, сосудистый и гломерулярный склероз, утрату тубулярных компонентов и интерстициальную лимфоцитарную инфильтрацию. Иммунофлуоресцентный тест выявляет слабое осаждение комплемента C3 и/или IgG, или IgM (преимущественно в мезангиуме). Таким образом, многие симптомы почечной недостаточности и хондрита могут быть ошибочно отнесены к рецидивирующему полихондриту вместо гранулематоза с полиангиитом или другого сопутствующего заболевания.
До настоящего времени не разработаны конкретные биомаркеры для оценки персистирующего повреждения хряща. Основной целью анализов крови является поиск сопутствующих заболеваний, выявление которых может помочь при дифференциальной диагностике. Биопсия хряща не имеет существенного значения при определении заболевания, но может быть полезной при ранних, атипичных формах, или неоднозначной клинической картине. Разрушение хряща с истощением протеогликана индуцируется, с одной стороны, плеоморфной перихондральной инфильтрацией лимфоцитов, моноцитов/макрофагов, плазматических и полиморфноядерных клеток, а с другой стороны — внутренними факторами, такими как определенные типы протеолитических и апоптозных ферментов (матричной металлопротеиназы-3 и катепсина-K).
Компьютерная/магнитно-резонансная томография, сцинтиграфия (с метилендифосфонатом 99 технеция или цитратом 67 галлия) и допплеровская эхокардиография выявляют аномалии ларинготрахеальнобронхиального дерева и аорты. Во многочисленных исследованиях показано значение позитронно-эмиссионной томографии с фтороксиглюкозой 18 фтора в качестве нового диагностического метода, который может быть полезен при раннем распознавании заболевания, ранней диагностике рецидивирующего полихондрита, а также при выявлении субклинического хондрита, оценке активности процесса, его обширности, при выборе места для прицельной биопсии и мониторинге терапевтического ответа. Наличие симметрично распределенных очагов поглощения фтороксиглюкозы с высоким содержанием 18 фтора в двух или более хрящах является потенциальным критерием диагностики.
До недавнего времени активность болезни оценивали по наличию клинических симптомов, определению острой фазы аутоиммунного процесса и методов визуализации, таких как ларингоскопия, костная сцинтиграфия, компьютерная томография или магнитно-резонансная томография трахеи. Биомаркеры, такие как неоэпитоп мочевого коллагена II типа, хрящевой олигомерный матричный белок и триггерный рецептор, экспрессируются в миелоидных клетках-1 и могут представлять интерес для оценки активности заболевания для выбора терапевтического решения. Значительное повышение уровня в сыворотке крови неоэпитопа расщепления коллагеназы коллагена II типа (маркер, отражающий деградацию коллагена II типа под действием коллагеназ) может наблюдаться во время активных фаз заболевания у пациентов, применяющих кортикостероиды.
Диагностика рецидивирующего полихондрита
Текущая диагностика рецидивирующего полихондрита основывается на наличии соответствующей клинической симптоматики и наличия по крайней мере трех из шести следующих критериев:
1) двусторонний аурикулярный хондрит;
2) неэрозивный серонегативный полиартрит;
3) носовой хондрит;
4) воспаление глаз;
5) хондрит дыхательных путей;
6) кохлеарная и/или вестибулярная дисфункция.
Развитие заболевания и прогноз
Развитие рецидивирующего полихондрита очень часто непрогнозируемо. В одном из недавних исследований не было выявлено корреляции между клиническими особенностями, острыми фазовыми состояниями и результатами визуализации. Большинство пациентов имеют низкую активность болезни со множественными вспышками. Рецидивы обычно связаны с одним и тем же участком, сопровождаются прогрессирующим разрушением хряща, инвалидизацией или даже полной потерей функций (слуха, остроты зрения). Часто развивается дисфония и сердечно-легочные события. С возрастом риск смертности у пациентов с рецидивирующим полихондритом повышается. Дополнительными критериями являются деформация седла носа, ларинготрахеальное поражение, артрит, системный васкулит и гематурия. У пациентов пожилого возраста даже анемия является негативным прогностическим критерием.
Лечение с позиции доказательной медицины
Различные терапевтические стратегии, используемые в настоящее время, являются эмпирическими и основаны на отдельных случаях заболевания. Несмотря на отсутствие клинических испытаний или подтвержденных рекомендаций, единственным препаратом при лечении пациентов с рецидивирующим полихондритом являются кортикостероиды. Их применение показано практически при всех проявлениях болезни на всех стадиях. Преднизон или его эквивалент способен вызвать полную ремиссию у некоторых пациентов. Кортикостероиды в высоких дозах или внутривенная импульсная терапия иногда необходимы во время рецидивов и состояний, угрожающих жизни или целостности органов. Ингаляционные кортикостероиды могут быть эффективными при обструктивных респираторных проявлениях, а также с целью снижения системных доз кортикостероидов. Внутриочаговое введение кортикостероидов также является альтернативой. Поддерживаемое интратимпаническое введение кортикостероидов может быть эффективным при сенсоневральной потере слуха. После угасания рецидива доза необходимых кортикостероидов может быть снижена, но большинству пациентов требуется постоянное воздействие этих препаратов в невысоких дозах. Это позволяет снизить частоту и тяжесть рецидивов, однако не влияет на прогрессирование заболевания и процесс вовлечения жизненно важных органов.
Резистентные к применению кортикостероидов и/или угрожающие жизни формы рецидивирующего полихондрита являются показанием для использования иммунодепрессантов или иммуномодулирующих препаратов. Они необходимы для контроля активности болезни и помогают придерживаться определенной дозы кортикостероидов, параллельно снижая частоту и выраженность побочных эффектов. Колхицин, дапсон, метотрексат, циклофосфамид, циклоспорин, хлорамбуцил, азатиоприн, микофенолят-мофетил, иммуноглобулины, миноциклин и лефлуномид эффективны у некоторых пациентов. Колхицин может быть полезен во время периодов ремиссии рецидивирующего полихондрита. Внутривенное введение циклофосфамида и плазмаферез эффективны при таких угрожающих жизни состояниях, как острая обструкция дыхательных путей, распространение процесса на глаза, гломерулонефрит. Инфекционные осложнения, связанные с иммуносупрессией и невыявленными рецидивами после прекращения применения иммунодепрессантов, в значительной степени ответственны за заболеваемость и смертность, отмечаемые у этих пациентов.
Среди пациентов с обструкцией трахеи, стриктурой или стенозом часто проводится трахеостомия. Впоследствии для спасения пациента иногда необходимы дилатация, стентирование и ассимиляция трахеи, а также восстановительные операции при обширных поражениях. Пневмоторакс и пневмомедиастинум могут развиться как побочные явления в результате стентирования. В случае сенсорной потери слуха кохлеарные имплантаты могут помочь его восстановлению. Деформирование седла носа может быть исправлено путем реконструктивных операций с костным трансплантатом из подвздошного гребня; аутоиммунный характер хондрита исключает репаративную трансплантацию хрящевой ткани из-за ожидаемого разрушения. Многим пациентам были предложены операции по замене сердечного клапана и хирургия по поводу аневризмы аорты.
Рецидивирующий полихондрит — редкое заболевание, которое в течение почти столетия хранило много секретов, бо`льшая часть из которых до сих пор не раскрыта. Проблемы остаются как в понимании его патофизиологии, так и в ранней диагностике, оценке активности, прогнозе и лечении заболевания. Возможные решения включают обмен данными о рецидивирующем полихондрите между мировыми информационными центрами. Кроме того, необходимо провести больше рандомизированных контролируемых испытаний для составления руководящих принципов лечения, основанных на фактических данных.
Рецидивирующий полихондрит
Рецидивирующий полихондрит – редкое эпизодическое воспалительное и деструктивное заболевание, первично поражающее хрящи уха и носа, но также способное поражать глаза, трахеобронхиальное дерево, клапаны сердца, почки, суставы, кожу и кровеносные сосуды. Диагноз устанавливают по совокупности результатов клинического, лабораторного и инструментального исследований. В редких случаях требуется также биопсия. Лечение проводят преднизолоном и иммуносупрессорами.
Рецидивирующий полихондрит отмечается с одинаковой частотой у мужчин и у женщин, начинается обычно в среднем возрасте. Ассоциация с ревматоидным артритом Ревматоидный артрит (РА) Ревматоидный артрит (РА) – хроническое системное аутоиммунное заболевание, поражающее прежде всего суставы. Патологические изменения при РА опосредовано цитокинами, хемокинами и металлопротеиназами. Прочитайте дополнительные сведения , системной красной волчанкой Системная красная волчанка (СКВ) Системная красная волчанка – хроническое мультисистемное воспалительное заболевание аутоиммунной природы; поражает преимущественно молодых женщин. Наиболее часто заболевание проявляется артралгиями. Прочитайте дополнительные сведенияСимптомы и признаки рецидивирующего полихондрита
Наиболее часто развиваются острая боль, эритема и отек хрящей ушной раковины. Поражение носовых хрящей является следующим по частоте проявлением болезни, как и изменения суставов, варьирующие от артралгий до симметричного и асимметричного недеформирующего артрита с вовлечением крупных и мелких суставов, с преимущественным поражением хондрокостальных сочленений и коленных суставов.
Следующими наиболее распространенными проявлениями в порядке уменьшения частоты являются воспалительные процессы:
Глаз (например, конъюнктивит, склерит, ирит, кератит, хориоретинит)
Хрящевой ткани гортани, трахеи или бронхов (вызывающие охриплость, кашель и чувствительность в области гортанного хряща)
Сердечно-сосудистой системы (например, аортальная регургитация, митральная регургитация, перикардит, миокардит, аневризмы аорты, аортит)
Приступы острого воспаления проходят в течение от нескольких недель до нескольких месяцев; через несколько лет отмечаются повторные атаки.
Прогрессирование заболевания может привести к деструкции опорных хрящей с развитием обвислых ушей; седловидной деформации носа; воронкообразной деформации грудной клетки; зрительных, слуховых и вестибулярных нарушений. Стеноз трахеи может стать причиной одышки, пневмонии или даже коллапса трахеи. Возможно развитие сопутствующего системного васкулита (лейкоцитокластический васкулит или подострый полиартериит), миелодиспластического синдрома, злокачественных опухолей.
Диагностика рецидивирующего полихондрита
Диагноз рецидивирующего полихондрита устанавливают при наличии у пациента как минимум 3 из следующих признаков:
двусторонний хондрит ушных раковин,
хондрит респираторного тракта,
слуховая или вестибулярная дисфункция
Биопсия пораженного хряща, чаще ушной раковины, может быть полезна, если по клиническим признакам диагноз установить не удается, но ее проведение редко требуется.
Лабораторные исследования неспецифичны, но они проводятся, когда необходимо помочь исключить другие заболевания. В синовиальной жидкости могут обнаруживаться неспецифичные признаки умеренного воспаления, которые позволяют исключить инфекционный процесс. Анализ крови может показать нормоцитарную нормохромную анемию, лейкоцитоз, повышение скорости оседания эритроцитов (СОЭ) или уровня гамма-глобулинов и иногда положительный ревматоидный фактор, антинуклеарные антитела (AHA), или у около 25% пациентов – антинейтрофильные цитоплазматические антитела (АНЦА). Нарушение функции почек может свидетельствовать об ассоциированном гломерулонефрите. Выявление цитоплазматических антинейтрофильных цитоплазматических антител (АНЦА, преимущественно связывающихся с протеиназой-3), предполагает наличие гранулематоза с полиангиитом Диагностика Гранулематоз с полиангиитом характеризуется некротизирующим гранулематозным воспалением, васкулитом с поражением сосудов малого и среднего калибра и очаговым некротизирующим гломерулонефритом. Прочитайте дополнительные сведенияПри установлении диагноза необходимо также исследовать верхние и нижние дыхательные пути, включая полное спирометрическое обследование и КТ грудной.
Прогноз при рецидивирующем полихондрите
Новые методы лечения позволили снизить уровень смертности от данного заболевания. Выживаемость после 8 лет болезни на сегодняшний день составляет 94%. Основные причины смерти – стеноз гортани и трахеи, а также сердечно-сосудистые осложнения, такие как аневризмы крупных сосудов, недостаточность сердечных клапанов или системные васкулиты.
Лечение рецидивирующего полихондрита
Нестероидные противовоспалительные препараты или дапсон при легкой форме поражения уха
В некоторых случаях метотрексат или другие иммуносупрессанты (например, циклоспорин, циклофосфамид, азатиоприн, препараты, подавляющие активность фактора некроза опухолей)
При легком рецидивирующем поражении уха может наблюдаться ответ на терапию нестероидными противовоспалительными препаратами в адекватных противовоспалительных дозах или на пероральный дапсон (50–100 мг 1 раз в день). Большинству пациентов показано пероральное назначение преднизолона в дозе от 30 до 60 мг 1 раз в день с последующим снижением дозы после достижения клинического улучшения. В отдельных случаях может потребоваться назначение длительной глюкокортикоидной терапии. У таких пациентов снижение дозы глюкокортикоидов возможно при комбинации их с пероральном метотрексатом в дозе от 7,5 до 20 мг в неделю. Очень тяжелые случаи заболевания могут потребовать применения других иммуносупрессантов, таких препаратов, как циклоспорин, циклофосфамид, ингибитор фактора некроза опухоли (например, инфликсимаб, этанерцепт) или азатиоприна ( Иммуномодулирующие, цитотоксические и иммунодепрессивные препараты Иммуномодулирующие, цитотоксические и иммунодепрессивные препараты Ревматоидный артрит (РА) – хроническое системное аутоиммунное заболевание, поражающее прежде всего суставы. Патологические изменения при РА опосредовано цитокинами, хемокинами и металлопротеиназами. Прочитайте дополнительные сведения При развтии более тяжелого трахиобронхиального коллапса может потребоваться реконструкция трахеи. Поражение глаз в ряде случаев бывает резистентным к лечению, особенно при вовлечении склеры, и прогноз в этих случаях обычно неблагоприятный. При проведении длительного лечения глюкокортикоидами пациентам следует проводить профилактику остеопороза Профилактика Остеопороз – прогрессирующее метаболическое заболевание кости, при котором происходит снижение ее минерализации (массы костной ткани на единицу объема), сопровождающееся нарушением ее структуры. Прочитайте дополнительные сведения Pneumocystis jirovecii (см. профилактика пневмонии, вызванной Pneumocystis jirovecii Профилактика Pneumocystis jirovecii – частая причина пневмонии у пациентов с иммунодефицитом, особенно у инфицированных вирусом иммунодефицита человека (ВИЧ) и получающих системные кортикостероиды. Прочитайте дополнительные сведенияИнтубация трахеи может быть технически затруднена по причине ее вовлечения в заболевание и сужения; также манипуляции на трахее могут привести к опасным для жизни посленаркозным осложнениям: воспаление голосовой щели и расположенных ниже дыхательных путей. Таким образом, интубации трахеи следует избегать, когда это возможно (например, использовать местную и региональную анестезию). Если интубация трахеи является неизбежной, следует быть готовым к ургентной крикотиреотомии.
Основные положения
Следует подозревать рецидивирующий полихондрит, если у пациента присутствует воспаление ушной раковины или носового хряща, особенно с симптомами и признаками, характерными для хондритов дыхательных путей или артрита неизвестной этиологии, воспаление глаз, слуховая или вестибулярная дисфункции.
Биопсия пораженного хряща выполняется только при необходимости подтверждения диагноза.
При легких формах поражения уха назначают нестероидные противовоспалительные препараты или дапсон.
Лечение более тяжелых форм заболевания начинают с приема кортикостероидов, иногда метотрексата или других иммуносупрессоров.
Избегайте эндотрахеальной интубации или, если это невозможно, подготовьтесь к ургентной крикотиреотомии.
Авторское право © 2022 Merck & Co., Inc., Rahway, NJ, США и ее аффилированные лица. Все права сохранены.
Читайте также: